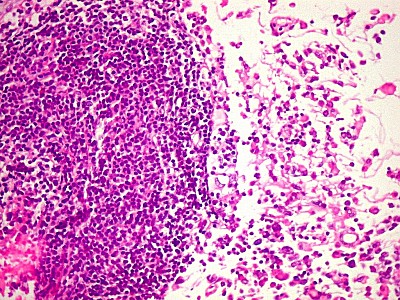

| Destaques
da imunohistoquímica.
As reações imunohistoquímicas demonstram a natureza
indiferenciada do tumor, pela positividade para vários antígenos,
como GFAP (astrócitos), antígenos musculares, epiteliais
e neuronais. A chave do diagnóstico é a negatividade
nas células tumorais do antígeno INI-1, positivo em células
não neoplásicas, como epêndima, vasos e células
do sangue. São células que não pertencem à
neoplasia, e sim a tecidos hospedeiros ou extrínsecos a ela. |
|
|
|
| VIM.
Positiva no citoplasma das células neoplásicas. Filamento
intermediário do citoplasma de expressão ubiquitária. |
Destaca
núcleo excêntrico, deslocado pelo corpúsculo rabdóide. |
VIM.
Positivo no epêndima do III ventrículo. Células neoplásicas
subjacentes. |
 |
 |
 |
|
|
|
| GFAP.
Positivo no tumor, negativo no folículo linfóide. Indica
expressão do filamento intermediário próprio de astrócitos. |
GFAP -
Positivo no epêndima e nas células neoplásicas. |
GFAP -
Positivo nas células neoplásicas, negativo em vasos com proliferação
endotelial. |
 |
 |
 |
|
|
|
| HHF-35
Actina sarcomérica, positiva nas células neoplásicas.
Indica diferenciação muscular. |
Desmina.
Filamento intermediário de fibras musculares esqueléticas. |
1A4.
Actina de músculo liso. Negativo no tumor, positivo em vasos
do mesmo (controle interno positivo). |
 |
 |
 |
|
|
|
| AE1AE3.
Pancitoqueratina, marca queratinas de alto e baixo peso molecular.
Indica diferenciação epitelial. |
AE1AE3,
positiva nas células ependimárias e nas células neoplásicas. |
EMA.
Antígeno epitelial de membrana. Também indica diferenciação
epitelial. |
 |
 |
 |
|
|
|
| EMA.
Positiva no tumor, negativa em vasos proliferados. |
EMA.
Positiva no epêndima do III ventrículo, inclusive em células
ciliadas. |
SNF.
Positivo em poucas células tumorais, indica diferenciação
neuronal. |
 |
 |
 |
|
|
|
| MAP2.
Positivo citoplasmático em todas células tumorais,
indica diferenciação neuronal |
S-100.
Marcador de células derivadas da crista neural, como células
de Schwann e melanócitos, positivo em parte das células
tumorais (marcação nuclear e citoplasmática). |
INI1.
Antígeno nuclear presente em todas as células normais.
Sua ausência é importante marcador do tumor teratóide
rabdóide atípico (metade direita do campo). Na metade
esquerda, vaso com células positivas. Os vasos não
pertencem ao tumor, mas o invadem a partir dos tecidos infiltrados. |
 |
 |
 |
|
|
|
| INI1.
Células neoplásicas negativas (centro) e epêndima positivo
(em cima) (não neoplásico) |
INI1.
Células vasculares INI1 positivas, células neoplásicas
negativas (embaixo) |
INI1. Linfócitos
positivos. Como células inflamatórias, não pertencem
ao tumor. |
 |
 |
 |
|
|
|
| CD3.
Marcador de linfócitos T, positivo no folículo linfóide,
negativo no tumor. |
CD20.
Marcador de linfócitos B, positivo no folículo linfóide,
negativo no tumor. |
CD68.
Marcador de macrófagos, positivo no tumor. Parte da positividade
refere-se a macrófagos, parte às células neoplásicas. |
 |
 |
 |
|
|
|
| CD34.
Positivo nos vasos, negativo no tumor |
Ki67.
Marca cerca de 90% dos núcleos neoplásicos, indicando altíssimo
índice proliferativo. |
p53.
Marca a totalidade dos núcleos neoplásicos, sugerindo mutação
do gene P53, que regula apoptose. |
 |
 |
 |
|
|
|